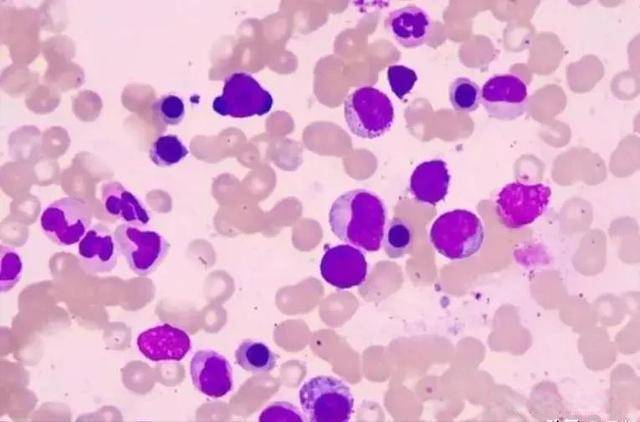

120万一针的抗癌药,深圳首例试用患者已奇迹康复,到底值不值?
在医学那波澜壮阔又荆棘密布的发展长河中,癌症宛如一座阴森且巍峨的 “死亡堡垒”,无情地矗立在人类健康的康庄大道上,无数鲜活的生命在其笼罩的阴影下苦苦挣扎、备受煎熬。而就在当下,一款被冠之以 “抗癌神药” 之名的 CAR - T 细胞治疗技术,以令人咋舌的一针 120 万天价,如同重磅炸弹般闯入大众的视野,瞬间成为全社会瞩目的焦点。这一价格,恰似一道难以跨越的天堑鸿沟,使得无数普通家庭只能望而却步、徒唤奈何。然而,在这令人咋舌的高昂价格背后,却是无数被癌症折磨得奄奄一息的患者心中重燃的希望之火。它究竟是能够彻底驱散癌魔阴霾、拯救万千生命的终极神兵利器,还是如同那绚丽夺目却脆弱易碎、转瞬即逝的梦幻泡沫?接下来,就让我们怀揣着敬畏与期待,一同走进几位患者跌宕起伏的抗癌历程,深度探寻这天价抗癌针背后那些动人心弦的故事。

戴阿姨,曾经在三尺讲台上默默耕耘、无私奉献了一生的辛勤园丁。本应在退休之后,尽情享受含饴弄孙、天伦之乐的美好时光,可命运却对她露出了狰狞的獠牙,癌症这头凶残的恶魔无情地缠上了她。历经一轮又一轮痛苦不堪的化疗,病情虽偶有短暂的缓解,但那如顽强野草般的肿瘤,很快便卷土重来,再度疯狂生长。右上臂和左臀部的肿瘤,犹如两座沉重的大山,压得戴阿姨日夜饱受折磨,痛苦到了极致,甚至一度让她萌生出放弃与病魔抗争的绝望念头。

然而,就在戴阿姨深陷绝望深渊、几乎要被黑暗完全吞噬之时,我国首个 CAR - T 细胞治疗药品获批上市的消息,宛如一道璀璨夺目的曙光,直直地穿透了那厚重的黑暗。怀揣着这最后一丝宝贵的希望,戴阿姨毅然决然地踏上了前往北大深圳医院的治疗之路。在那里,一场充满未知与挑战的复杂精细治疗流程徐徐展开:淋巴细胞采集、CAR - T 细胞制备与回输,每一个步骤都如同在悬崖边缘行走,充满了不确定性与艰难险阻。
展开全文
但奇迹总是在不经意间降临,几个月后,戴阿姨身上发生了翻天覆地的变化。她的症状大幅缓解,复查结果更是令人惊喜万分 —— 淋巴瘤完全消失了!那一刻,戴阿姨和她的家人喜极而泣,泪水夺眶而出。CAR - T 细胞治疗技术就如同那根拥有神奇魔力的重生魔杖,让戴阿姨重新拥抱了生活。戴阿姨感慨万千地说道:“是这个伟大的时代,还有那些默默奉献的科研人员,给了我活下去的勇气,让我重获新生。”
郑女士,在职场上是一位雷厉风行、叱咤风云的女强人。她的事业一路高歌猛进、蒸蒸日上,各种荣誉纷至沓来、加诸其身。然而,癌症的突袭,却如同一场突如其来的暴风雨,瞬间将她原本平静美好的生活击得粉碎。弥漫大 B 细胞淋巴瘤的确诊,犹如一道晴天霹雳,让她陷入了无尽的痛苦与绝望之中。多次化疗均未能有效地遏制病情的发展,身心俱疲的郑女士几乎要被病魔彻底击垮。

但郑女士骨子里就有着一股不服输的坚韧劲儿,当听闻 CAR - T 细胞治疗技术时,她没有丝毫的犹豫,果断地选择尝试。在上海瑞金医院,治疗过程艰难重重,犹如在荆棘丛中艰难前行。但郑女士凭借着惊人的毅力和顽强的精神,不仅积极主动地配合治疗,还成为了病友们的精神支柱。她用自己乐观向上的态度和温暖有力的鼓励,如同火炬一般,为病友们传递着正能量,照亮了大家在黑暗中前行的道路。
几个月的咬牙坚持之后,曙光终于来临。复查结果显示,郑女士的肿瘤得到了缓解。那一刻,郑女士激动得热泪盈眶,她泣不成声地说道:“CAR - T 救了我的命,更重要的是,让我重新找回了生活的信心。我相信,只要我们心怀希望,积极勇敢地面对病魔,就一定能够战胜它,重回美好的生活。” 郑女士用自己的亲身经历,向我们生动地诠释了希望的力量和人类顽强不屈的精神。
任大爷,一位勤劳朴实了一辈子的退休工人。本应在晚年过上安逸宁静的生活,尽享岁月的静好,可恶性肿瘤且多病灶的噩耗,却如同一场无情的灾难,瞬间打乱了他的生活节奏。家人带着任大爷四处求医问药,却始终无果,一家人陷入了深深的绝望之中。

直到有一天,他们得知嘉兴一院采用了 CAR - T 细胞治疗技术,仿佛在黑暗中看到了一丝微弱却珍贵的希望之光。在医院里,任大爷历经了淋巴细胞采集、CAR - T 细胞制备与回输等一系列复杂而痛苦的治疗过程。尽管每一步都充满了艰辛,身体承受着巨大的痛苦,但任大爷始终保持着乐观坚定的信念,从未有过一丝放弃的念头。
几个月后,好消息传来,任大爷的肿瘤得到了缓解。这个消息让任大爷重燃生活的希望,他激动得声音颤抖地说:“真没想到我还能活下来,CAR - T 给了我第二次生命,让我又有机会看看这美好的世界。” 任大爷的经历告诉我们,无论面对多大的困难和挑战,只要我们不放弃,就永远有战胜病魔的可能。

随着 CAR - T 细胞治疗技术逐渐为大众所熟知,越来越多的癌症患者看到了治愈的希望之光。然而,那高达 120 万的天价,却如同一块沉重的巨石,压在了无数患者和家庭的心头,让大多数人只能无奈地望 “药” 兴叹。
目前,我国已经有六款 CAR - T 产品成功上市。尽管在四次冲刺国家医保的征程中遭遇失败,但令人欣慰的是,今年有四款产品已通过初步形式审查,这无疑给广大患者带来了一丝希望的曙光。那么,究竟是什么原因导致 CAR - T 细胞治疗技术如此昂贵呢?
这一切都源于其独特的个性化细胞疗法特性。CAR - T 治疗需要根据每一位患者的个体差异,量身定制专属的治疗方案。从淋巴细胞采集的精准操作,到 CAR - T 细胞制备过程中的精细培育,再到最后的回输环节,每一步都高度依赖高精尖的医疗设备,同时也离不开专业医护团队的精心呵护与全程陪伴。整个过程耗费了大量的时间、人力和物力资源,成本自然而然地居高不下。

不过,值得庆幸的是,随着医疗科技的日新月异以及相关政策的不断完善与优化,我们完全有理由期待 CAR - T 细胞治疗技术的费用能够逐渐降低,从而惠及更多在病痛中挣扎的癌症患者。
癌症,作为人类健康的头号公敌,一直以来都在无情地考验着我们的勇气、智慧和毅力。CAR - T 细胞治疗技术的横空出世,无疑为我们漫长而艰辛的抗癌之路注入了全新的活力与希望。戴阿姨、郑女士和任大爷等众多患者的成功案例,宛如一盏盏明灯,让我们真切地看到了生命的顽强不屈以及医学的伟大力量。
尽管目前 CAR - T 细胞治疗技术面临着诸如高昂费用等诸多严峻的挑战,但我们坚信,在科研人员夜以继日的不懈努力下,在政策制定者的持续推动下,随着科研的不断深入推进以及政策的持续优化调整,CAR - T 细胞治疗技术必将逐渐走向普及,为更多的癌症患者带来生的希望与福音

每一个抗癌故事,都是生命与病魔之间惊心动魄的顽强抗争,它们如同激昂的战歌,激励着我们每一个人。只要我们始终不放弃希望,积极勇敢地探索前行,就一定能够在与癌症的这场殊死战斗中取得最终的胜利,让生命之光在这片土地上永远璀璨闪耀。









评论